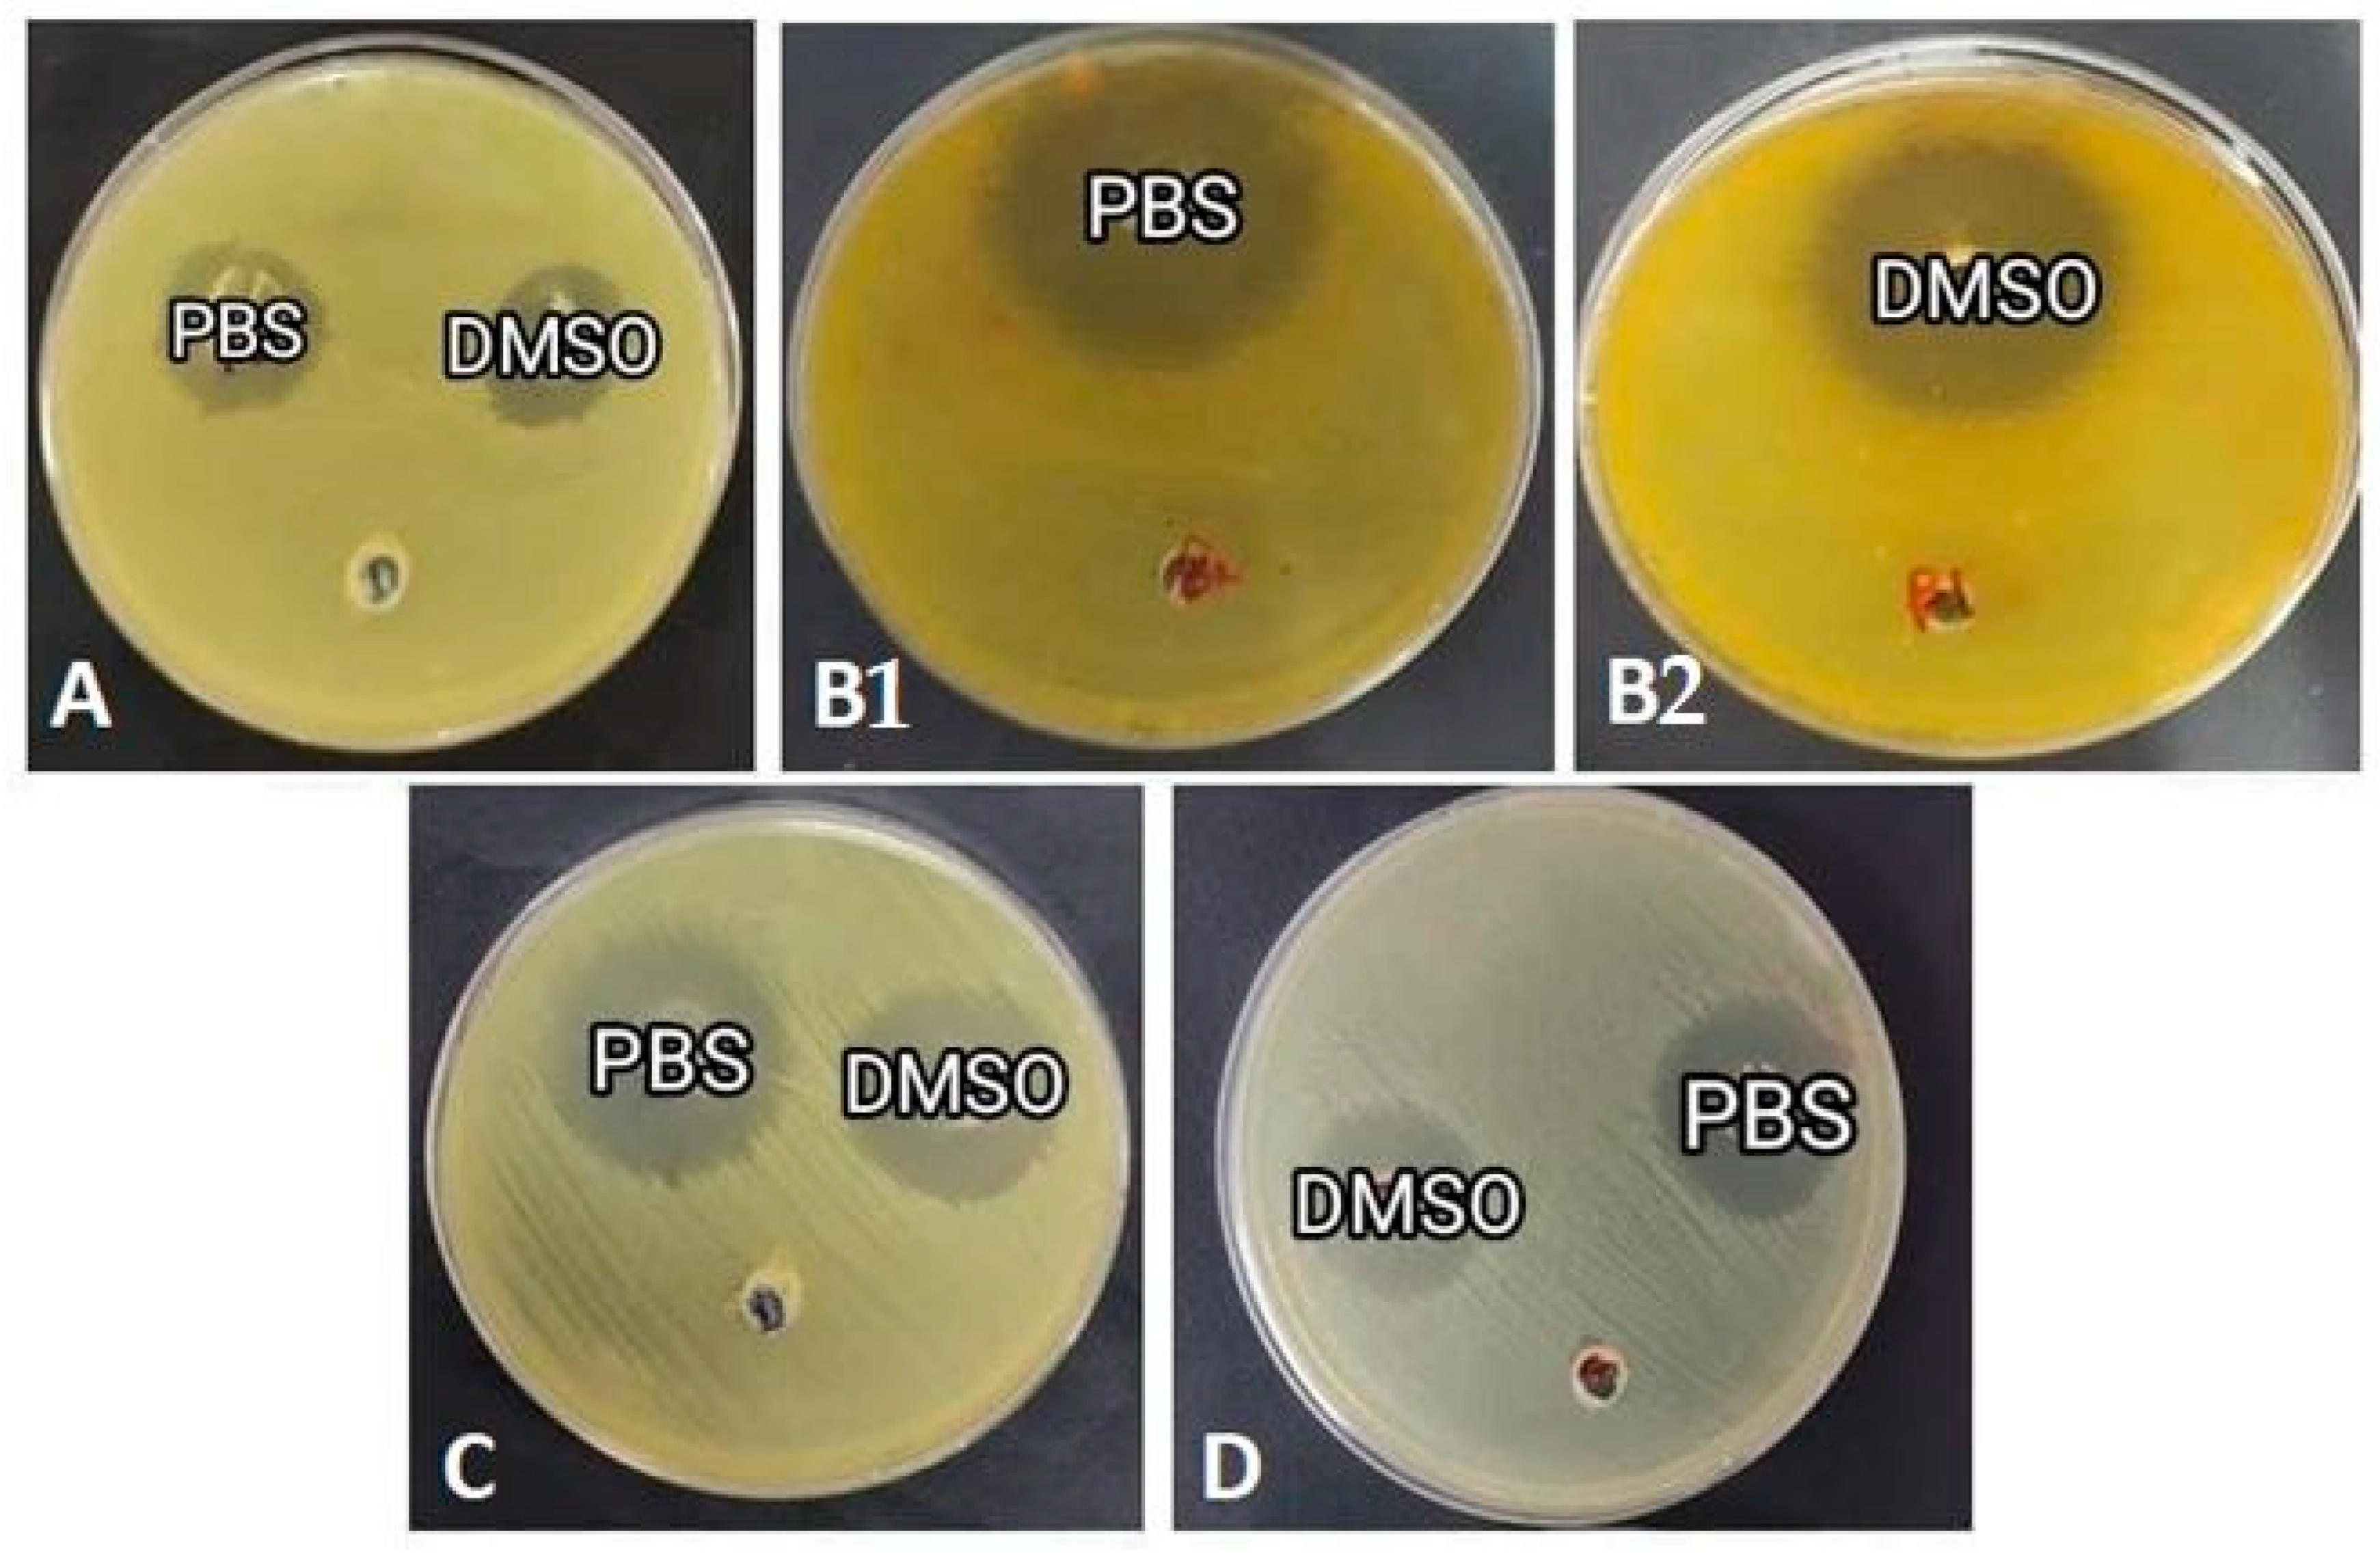

Intraspecific Variability in Proteomic Profiles and Biological Activities of the Honey Bee Hemolymph
Abstract
Simple Summary
Abstract
1. Introduction
2. Materials and Methods
2.1. Chemicals
2.2. Sample Collection and Preparation
2.3. Hemolymph Collection and Preparation
2.4. Protein Estimation
2.5. SDS-Polyacrylamide Gel Electrophoresis
2.6. HPLC (High-Performance Liquid Chromatography) Analysis
2.7. Anticancer Activity (MTT-Assay)
2.8. Antimicrobial Activity Screening
2.9. DPPH Radical Scavenging Assay
2.10. Hemolytic Activity Assay
2.11. Statistical Analysis
3. Results
3.1. Naturally Fed Honey Bees Had Higher Protein Concentrations in Hemolymph
3.2. Honey Bee Hemolymph Showed Different Protein Composition across Sites
3.3. HPLC Analyses Were Then Used to Separate the Proteins of the Hemolymph Extracts According to Their Peaks Expressed in Retention Time
3.4. Honey Bee Hemolymph Suppresses the Growth of HepG2 and HeLa Cells
3.5. Honey Bee Hemolymph Inhibits the Growth of Gram-Positive and Gram-Negative Bacteria
3.6. Honey Bee Hemolymph Scavenges DPPH Free Radical
3.7. Honey Bees Possess Low Hemolytic Activity against Human Erythrocytes
4. Discussion
5. Conclusions
Supplementary Materials
Author Contributions
Funding
Data Availability Statement
Acknowledgments
Conflicts of Interest
References
- Park, M.G.; Orr, M.C.; Danforth, B.N. The Role of Native Bees in Apple Pollination. Number 2010, 18, 5. [Google Scholar]
- Naggar, Y.A.; Codling, G.; Giesy, J.P.; Safer, A. Beekeeping and the Need for Pollination from an Agricultural Perspective in Egypt. Bee World 2018, 95, 107–112. [Google Scholar] [CrossRef]
- Winfree, R. The conservation and restoration of wild bees: Wild bee conservation. Ann. N. Y. Acad. Sci. 2010, 1195, 169–197. [Google Scholar] [CrossRef]
- Marchal, P.; Buatois, A.; Kraus, S.; Klein, S.; Gomez-Moracho, T.; Lihoreau, M. Automated monitoring of bee behaviour using connected hives: Towards a computational apidology. Apidologie 2020, 51, 356–368. [Google Scholar] [CrossRef]
- Horvatinec, J.; Svečnjak, L. Infrared (FTIR) spectral features of honey bee (Apis mellifera L.) hemolymph. J. Cent. Eur. Agric. 2020, 21, 37–41. [Google Scholar] [CrossRef]
- Hou, Y.; Zhang, Y.; Gong, J.; Tian, S.; Li, J.; Dong, Z.; Guo, C.; Peng, L.; Zhao, P.; Xia, Q. Comparative proteomics analysis of silkworm hemolymph during the stages of metamorphosis via liquid chromatography and mass spectrometry. Proteomics 2016, 16, 1421–1431. [Google Scholar] [CrossRef]
- Ashrafuzzaman, M.; Razu, M.H.; Showva, N.-N.; Bondhon, T.A.; Moniruzzaman, M.; Rahman, S.A.R.; Rabby, M.R.I.; Akter, F.; Khan, M. Biomolecules of the Horseshoe Crab’s Hemolymph: Components of an Ancient Defensive Mechanism and Its Impact on the Pharmaceutical and Biomedical Industry. Cell. Microbiol. 2022, 2022, e3381162. [Google Scholar] [CrossRef]
- Strachecka, A.; Krauze, M.; Olszewski, K.; Borsuk, G.; Paleolog, J.; Merska, M.; Chobotow, J.; Bajda, M.; Grzywnowicz, K. Unexpectedly strong effect of caffeine on the vitality of western honeybees (Apis mellifera). Biochem. Biokhimiia 2014, 79, 1192–1201. [Google Scholar] [CrossRef]
- Cremonz, T.M.; De Jong, D.; Bitondi, M.M.G. Quantification of Hemolymph Proteins as a Fast Method for Testing Protein Diets for Honey Bees (Hymenoptera: Apidae). J. Econ. Entomol. 1998, 91, 1284–1289. [Google Scholar] [CrossRef]
- De Jong, D.; da Silva, E.J.; Kevan, P.G.; Atkinson, J.L. Pollen substitutes increase honey bee haemolymph protein levels as much as or more than does pollen. J. Apic. Res. 2009, 48, 34–37. [Google Scholar] [CrossRef]
- DeGrandi-Hoffman, G.; Eckholm, B.J.; Huang, M.H. A comparison of bee bread made by Africanized and European honey bees (Apis mellifera) and its effects on hemolymph protein titers. Apidologie 2013, 44, 52–63. [Google Scholar] [CrossRef]
- Feng, M.; Ramadan, H.; Han, B.; Fang, Y.; Li, J. Hemolymph proteome changes during worker brood development match the biological divergences between western honey bees (Apis mellifera) and eastern honey bees (Apis cerana). BMC Genomics 2014, 15, 563. [Google Scholar] [CrossRef] [PubMed]
- Basualdo, M.; Barragán, S.; Antúnez, K. Bee bread increases honey bee haemolymph protein and promote better survival despite of causing higher Nosema ceranae abundance in honey bees. Environ. Microbiol. Rep. 2014, 6, 396–400. [Google Scholar] [CrossRef] [PubMed]
- Cabbri, R.; Ferlizza, E.; Nanetti, A.; Monari, E.; Andreani, G.; Galuppi, R.; Isani, G. Biomarkers of nutritional status in honeybee haemolymph: Effects of different biotechnical approaches for Varroa destructor treatment and wintering phase. Apidologie 2018, 49, 606–618. [Google Scholar] [CrossRef]
- Mokarramat-Yazdi, A.; Soltaninejad, H.; Zardini, H.; Shishehbor, F.; Alemi, A.; Fesahat, F.; Sadeghian, F. Investigating the anticancer effect of a new drug originating from plant and animal: In vitro and in vivo study. J. Adv. Pharm. Educ. Res. 2021, 10, 72–78. [Google Scholar]
- Chan, Q.W.T.; Howes, C.G.; Foster, L.J. Quantitative Comparison of Caste Differences in Honeybee Hemolymph. Mol. Cell. Proteom. 2006, 5, 2252–2262. [Google Scholar] [CrossRef] [PubMed]
- Pace, C.N.; Treviño, S.; Prabhakaran, E.; Scholtz, J.M. Protein structure, stability and solubility in water and other solvents. Philos. Trans. R. Soc. Lond. B Biol. Sci. 2004, 359, 1225–1234, discussion 1234–1235. [Google Scholar] [CrossRef] [PubMed]
- Tutun, H.; Sevin, S.; Çetintav, B. Effects of different chilling procedures on honey bees (Apis mellifera) for anesthesia. Ank. Üniversitesi Vet. Fakültesi Derg. 2020, 67, 289–294. [Google Scholar] [CrossRef]
- Łoś, A.; Strachecka, A. Fast and Cost-Effective Biochemical Spectrophotometric Analysis of Solution of Insect “Blood” and Body Surface Elution. Sensors 2018, 18, 1494. [Google Scholar] [CrossRef]
- Basseri, H.R.; Dadi-Khoeni, A.; Bakhtiari, R.; Abolhassani, M.; Hajihosseini-Baghdadabadi, R. Isolation and Purification of an Antibacterial Protein from Immune Induced Haemolymph of American Cockroach, Periplaneta americana. J. Arthropod-Borne Dis. 2016, 10, 519–527. [Google Scholar]
- Desjardins, P.; Hansen, J.B.; Allen, M. Microvolume Protein Concentration Determination Using the NanoDrop 2000c Spectrophotometer. J. Vis. Exp. 2009, 33, e1610. [Google Scholar] [CrossRef]
- Laemmli, U.K. Cleavage of Structural Proteins during the Assembly of the Head of Bacteriophage T4. Nature 1970, 227, 680–685. [Google Scholar] [CrossRef] [PubMed]
- Mosmann, T. Rapid colorimetric assay for cellular growth and survival: Application to proliferation and cytotoxicity assays. J. Immunol. Methods 1983, 65, 55–63. [Google Scholar] [CrossRef] [PubMed]
- Magaldi, S.; Mata-Essayag, S.; Hartung de Capriles, C.; Perez, C.; Colella, M.T.; Olaizola, C.; Ontiveros, Y. Well diffusion for antifungal susceptibility testing. Int. J. Infect. Dis. 2004, 8, 39–45. [Google Scholar] [CrossRef]
- Espinel-Ingroff, A.; Canton, E.; Fothergill, A.; Ghannoum, M.; Johnson, E.; Jones, R.N.; Ostrosky-Zeichner, L.; Schell, W.; Gibbs, D.L.; Wang, A.; et al. Quality Control Guidelines for Amphotericin B, Itraconazole, Posaconazole, and Voriconazole Disk Diffusion Susceptibility Tests with Nonsupplemented Mueller-Hinton Agar (CLSI M51-A Document) for Nondermatophyte Filamentous Fungi. J. Clin. Microbiol. 2011, 49, 2568–2571. [Google Scholar] [CrossRef]
- Espinel-Ingroff, A.; Arthington-Skaggs, B.; Iqbal, N.; Ellis, D.; Pfaller, M.A.; Messer, S.; Rinaldi, M.; Fothergill, A.; Gibbs, D.L.; Wang, A. Multicenter evaluation of a new disk agar diffusion method for susceptibility testing of filamentous fungi with voriconazole, posaconazole, itraconazole, amphotericin B, and caspofungin. J. Clin. Microbiol. 2007, 45, 1811–1820. [Google Scholar] [CrossRef]
- Braca, A.; De Tommasi, N.; Di Bari, L.; Pizza, C.; Politi, M.; Morelli, I. Antioxidant Principles from Bauhinia t arapotensis. J. Nat. Prod. 2001, 64, 892–895. [Google Scholar] [CrossRef]
- Hasan, S.M.R.; Jamila, M.; Majumder, M.M.; Akter, R.; Hossain, M.M.; Mazumder, M.E.H.; Alam, M.A.; Jahangir, R.; Rana, M.S.; Arif, M.; et al. Analgesic and Antioxidant Activity of the Hydromethanolic Extract of Mikania scandens (L.) Willd. Leaves. Am. J. Pharmacol. Toxicol. 2009, 4, 1–7. [Google Scholar] [CrossRef]
- Sathishkumar, T.; Baskar, R.; Shanmugam, S.K.; Rajasekaran, P.; Sadasivam, S.; Manikandan, V. Optimization of Flavonoids Extraction from the Leaves of Tabernaemontana heyneana Wall Using L16 Orthogonal Design. Nat. Sci. 2008, 6, 10–21. [Google Scholar] [CrossRef]
- Malagoli, D. A full-length protocol to test hemolytic activity of palytoxin on human erythrocytes. Invertebr. Surviv. J. 2007, 4, 92–94. [Google Scholar]
- DeGrandi-Hoffman, G.; Chen, Y.; Huang, E.; Huang, M.H. The effect of diet on protein concentration, hypopharyngeal gland development and virus load in worker honey bees (Apis mellifera L.). J. Insect Physiol. 2010, 56, 1184–1191. [Google Scholar] [CrossRef] [PubMed]
- El Mohandes, S.; Nafea, E.; Fawzy, A. Effect of different feeding diets on the haemolymph of the newly emerged honeybee workers Apis mellifera L. Egypt. Acad. J. Biol. Sci. Entomol. 2010, 3, 113–220. [Google Scholar] [CrossRef]
- Leta, M.A.; Gilbert, C.; Morse, R.A. Levels of hemolymph sugars and body glycogen of honeybees (Apis mellifera L.) from colonies preparing to swarm. J. Insect Physiol. 1996, 42, 239–245. [Google Scholar] [CrossRef]
- Kunc, M.; Dobeš, P.; Hurychová, J.; Vojtek, L.; Poiani, S.B.; Danihlík, J.; Havlík, J.; Titěra, D.; Hyršl, P. The Year of the Honey Bee (Apis mellifera L.) with Respect to Its Physiology and Immunity: A Search for Biochemical Markers of Longevity. Insects 2019, 10, 244. [Google Scholar] [CrossRef]
- Noordyke, E.; Ellis, J. Reviewing the Efficacy of Pollen Substitutes as a Management Tool for Improving the Health and Productivity of Western Honey Bee (Apis mellifera) Colonies. Front. Sustain. Food Syst. 2021, 5, 772897. [Google Scholar] [CrossRef]
- Smart, M.D.; Otto, C.R.V.; Lundgren, J.G. Nutritional status of honey bee (Apis mellifera L.) workers across an agricultural land-use gradient. Sci. Rep. 2019, 9, 16252. [Google Scholar] [CrossRef]
- Schulz, M.; Łoś, A.; Grzybek, M.; Ścibior, R.; Strachecka, A. Piperine as a new natural supplement with beneficial effects on the life-span and defence system of honeybees. J. Agric. Sci. 2019, 157, 140–149. [Google Scholar] [CrossRef]
- Skowronek, P.; Wójcik, Ł.; Strachecka, A. Cannabis Extract Has a Positive–Immunostimulating Effect through Proteolytic System and Metabolic Compounds of Honey Bee (Apis mellifera) Workers. Animals 2021, 11, 2190. [Google Scholar] [CrossRef]
- Strachecka, A.J.; Olszewski, K.; Paleolog, J. Curcumin Stimulates Biochemical Mechanisms of Apis mellifera Resistance and Extends the Apian Life-Span. J. Apic. Sci. 2015, 59, 129–141. [Google Scholar] [CrossRef]
- Nugraha, R.; Ruethers, T.; Johnston, E.B.; Rolland, J.M.; O’Hehir, R.E.; Kamath, S.D.; Lopata, A.L. Effects of Extraction Buffer on the Solubility and Immunoreactivity of the Pacific Oyster Allergens. Foods 2021, 10, 409. [Google Scholar] [CrossRef]
- Arakawa, T. Acetonitrile as solvent for protein interaction analysis. Int. J. Biol. Macromol. 2018, 114, 728–732. [Google Scholar] [CrossRef] [PubMed]
- Viswambari Devi, R.; Basilrose, M.R.; Mercy, P.D. Prospect for lectins in arthropods. Ital. J. Zool. 2010, 77, 254–260. [Google Scholar] [CrossRef]
- Pathak, J.P.N. Haemagglutinins (Lectins) in Insects. In Insect Immunity; Pathak, J.P.N., Ed.; Series Entomologica; Springer: Dordrecht, The Netherlands, 1993; pp. 149–169. [Google Scholar] [CrossRef]
- Xia, X.; You, M.; Rao, X.-J.; Yu, X.-Q. Insect C-type lectins in innate immunity. Dev. Comp. Immunol. 2018, 83, 70–79. [Google Scholar] [CrossRef] [PubMed]
- Cheung, R.C.F.; Wong, J.H.; Pan, W.; Chan, Y.S.; Yin, C.; Dan, X.; Ng, T.B. Marine lectins and their medicinal applications. Appl. Microbiol. Biotechnol. 2015, 99, 3755–3773. [Google Scholar] [CrossRef]
- Eleftherianos, I.; Zhang, W.; Heryanto, C.; Mohamed, A.; Contreras, G.; Tettamanti, G.; Wink, M.; Bassal, T. Diversity of insect antimicrobial peptides and proteins—A functional perspective: A review. Int. J. Biol. Macromol. 2021, 191, 277–287. [Google Scholar] [CrossRef]
- Fujii, Y.; Dohmae, N.; Takio, K.; Kawsar, S.M.A.; Matsumoto, R.; Hasan, I.; Koide, Y.; Kanaly, R.A.; Yasumitsu, H.; Ogawa, Y.; et al. A Lectin from the Mussel Mytilus galloprovincialis Has a Highly Novel Primary Structure and Induces Glycan-mediated Cytotoxicity of Globotriaosylceramide-expressing Lymphoma Cells. J. Biol. Chem. 2012, 287, 44772–44783. [Google Scholar] [CrossRef] [PubMed]
- M. Zakzok Et al., S. Antiproliferative and antioxidant activities of the edible crab Callinectes sapidus hepatopancreas and hemolymph extracts. Egypt. J. Aquat. Biol. Fish. 2021, 25, 531–550. [Google Scholar] [CrossRef]
- Pinto, I.R.; Chaves, H.V.; Vasconcelos, A.S.; de Sousa, F.C.F.; Santi-Gadelha, T.; de Lacerda, J.T.J.G.; Ribeiro, K.A.; Freitas, R.S.; Maciel, L.M.; Filho, S.M.P.; et al. Antiulcer and Antioxidant Activity of a Lectin from Mucuna pruriens Seeds on Ethanol- induced Gastropathy: Involvement of Alpha-2 Adrenoceptors and Prostaglandins. Curr. Pharm. Des. 2019, 25, 1430–1439. [Google Scholar] [CrossRef]
- Zakzok, S.M.; El-Ghany, A.G.A.; Anas, A.Y.; Dahshan, S.K. Biometric study, sex ratio and potential biological activities of the edible mantis shrimp Erugosquilla massavensis. Egypt. J. Aquat. Biol. Fish. 2022, 26, 229–253. [Google Scholar] [CrossRef]
- Guo, D.; Wang, H.; Zeng, D.; Li, X.; Fan, X.; Li, Y. Vaccine potential of hemocyanin from Oncomelania hupensis against Schistosoma Japonicum. Parasitol. Int. 2011, 60, 242–246. [Google Scholar] [CrossRef]
- Danty, E.; Arnold, G.; Burmester, T.; Huet, J.C.; Huet, D.; Pernollet, J.C.; Masson, C. Identification and developmental profiles of hexamerins in antenna and hemolymph of the honeybee, Apis mellifera. Insect Biochem. Mol. Biol. 1998, 28, 387–397. [Google Scholar] [CrossRef] [PubMed]
- Barchuk, A.R.; Bitondi, M.M.G.; Simões, Z.L.P. Effects of juvenile hormone and ecdysone on the timing of vitellogenin appearance in hemolymph of queen and worker pupae of Apis mellifera. J. Insect Sci. 2002, 2, 1. [Google Scholar] [CrossRef] [PubMed]
- Wheeler, D.E.; Kawooya, J.K. Purification and characterization of honey bee vitellogenin. Arch. Insect Biochem. Physiol. 1990, 14, 253–267. [Google Scholar] [CrossRef] [PubMed]
- Park, H.G.; Lee, K.S.; Kim, B.Y.; Yoon, H.J.; Choi, Y.S.; Lee, K.Y.; Wan, H.; Li, J.; Jin, B.R. Honeybee (Apis cerana) vitellogenin acts as an antimicrobial and antioxidant agent in the body and venom. Dev. Comp. Immunol. 2018, 85, 51–60. [Google Scholar] [CrossRef]
- Robbs, S.L.; Ryan, R.O.; Schmidt, J.O.; Keim, P.S.; Law, J.H. Lipophorin of the larval honeybee, Apis mellifera L. J. Lipid Res. 1985, 26, 241–247. [Google Scholar] [CrossRef]
- Ba, S.; Ro, R.; Jo, S.; Jh, L. Purification and properties of a very high density lipoprotein from the hemolymph of the honeybee Apis mellifera. Biochemistry 1987, 26, 1885–1889. [Google Scholar] [CrossRef]
- Ayyad, M.A.; Fakhry, A.M.; Moustafa, A.-R.A. Plant biodiversity in the Saint Catherine area of the Sinai peninsula, Egypt. Biodivers. Conserv. 2000, 9, 265–281. [Google Scholar] [CrossRef]
- Boulos, L. Flora and Vegetation of the Deserts of Egypt. Flora Mediterr. 2008, 18, 341–359. [Google Scholar]
- El-Seedi, H.R.; Burman, R.; Mansour, A.; Turki, Z.; Boulos, L.; Gullbo, J.; Göransson, U. The traditional medical uses and cytotoxic activities of sixty-one Egyptian plants: Discovery of an active cardiac glycoside from Urginea maritima. J. Ethnopharmacol. 2013, 145, 746–757. [Google Scholar] [CrossRef]
- Rabei, S.; Khedr, A.; Elgamal, I. Floristic study of Saint Katherine protectorate, Sinai: With one new record to flora of Egypt. Taeckholmia 2021, 41, 32–55. [Google Scholar] [CrossRef]
- Bogaerts, A.; Baggerman, G.; Vierstraete, E.; Schoofs, L.; Verleyen, P. The hemolymph proteome of the honeybee: Gel-based or gel-free? Proteomics 2009, 9, 3201–3208. [Google Scholar] [CrossRef] [PubMed]
- Mattila, H.R.; Otis, G.W. Effects of Pollen Availability and Nosema Infection during the Spring on Division of Labor and Survival of Worker Honey Bees (Hymenoptera: Apidae). Environ. Entomol. 2006, 35, 708–717. [Google Scholar] [CrossRef]
- Foley, K.; Fazio, G.; Jensen, A.B.; Hughes, W.O.H. Nutritional limitation and resistance to opportunistic Aspergillus parasites in honey bee larvae. J. Invertebr. Pathol. 2012, 111, 68–73. [Google Scholar] [CrossRef] [PubMed]
- Omar, E.M.; Darwish, H.Y.A.; Othman, A.A.; El-Seedi, H.R.; Al Naggar, Y. Crushing corn pollen grains increased diet digestibility and hemolymph protein content while decreasing honey bee consumption. Apidologie 2022, 53, 52. [Google Scholar] [CrossRef]

| Symbol | Locality | Main Feeding Diet | Main Plantation |
|---|---|---|---|
| A | Port said Governorate 31.259 N 32.27 E | Artificial (Sucrose syrup) | N.A |
| B | Ismailia Governorate 30.61 N 32.25 E | Natural | Cotton |
| C | Suez Governorate 30.02 N 32.34 E | Natural | Corn, cucumber, okra and sesame |
| D | Saint Catherine 28.56 N 33.94 E | Natural | Medicinal plants (thyme and sial tree) |
| Retention Time (min) | Peak Area (×102 mV.s) | |||||||
|---|---|---|---|---|---|---|---|---|
| A | B | C | D | |||||
| PBS | DMSO | PBS | DMSO | PBS | DMSO | PBS | DMSO | |
| 2.9 | N.A | N.A | 1.8 | N.A | 12.3 | N.A | N.A | N.A |
| 4.0 | N.A | N.A | N.A | 27.7 | N.A | 1167 | N.A | 0.2 |
| 4.3 | N.A | N.A | N.A | N.A | 14.4 | N.A | 3386 | N.A |
| 5.0 | N.A | N.A | N.A | 838.7 | N.A | N.A | N.A | 397 |
| 6.7 | 36.4 | N.A | 3.9 | N.A | 1.0 | N.A | N.A | N.A |
| 7.6 | N.A | N.A | 4.6 | N.A | 0.8 | N.A | 163.5 | N.A |
| 10.3 | N.A | N.A | N.A | N.A | 4.8 | N.A | 247.5 | N.A |
| 11.3 | N.A | N.A | 2.3 | N.A | 3.9 | N.A | N.A | N.A |
| 12.4 | N.A | N.A | 10.9 | N.A | 2.5 | N.A | 1265 | N.A |
| 14.4 | N.A | N.A | 5.9 | N.A | N.A | N.A | 105.3 | N.A |
| 19.9 | N.A | N.A | 4.1 | N.A | 5.0 | N.A | 363.7 | N.A |
| 22.1 | N.A | 0.3 | N.A | 1.5 | N.A | 0.6 | N.A | 2.6 |
| 23.2 | N.A | N.A | N.A | 3.6 | N.A | 1.0 | N.A | N.A |
| 23.5 | N.A | 0.9 | N.A | N.A | N.A | N.A | N.A | 1.2 |
| 25.6 | N.A | N.A | 9.1 | N.A | 18.0 | N.A | 770.9 | N.A |
| 28.7 | N.A | 0.6 | N.A | 2.6 | N.A | 0.3 | N.A | 1.8 |
| 28.8 | 43.2 | N.A | 2.3 | N.A | 4.7 | N.A | N.A | N.A |
| 30.3 | 94.8 | N.A | 1.8 | N.A | 5.2 | N.A | N.A | N.A |
| 30.4 | N.A | 1.3 | N.A | 0.5 | N.A | 0.2 | N.A | 0.4 |
| 33.2 | N.A | 0.2 | N.A | 0.3 | N.A | 0.3 | N.A | 0.2 |
| 34.8 | N.A | N.A | N.A | 0.8 | N.A | N.A | N.A | 1.4 |
| 36.5 | N.A | 1.0 | N.A | 0.7 | N.A | N.A | N.A | 0.2 |
| 38.1 | N.A | N.A | 9.1 | N.A | 3.0 | N.A | N.A | N.A |
| 38.7 | N.A | 10.5 | N.A | 0.2 | N.A | 0.1 | N.A | 0.1 |
| 40.7 | N.A | N.A | N.A | 0.1 | N.A | N.A | N.A | 0.1 |
| 43.0 | N.A | N.A | 4.4 | N.A | 2.6 | N.A | 99.1 | N.A |
| 47.7 | N.A | N.A | 14.6 | N.A | 10.7 | N.A | N.A | N.A |
| Sample | PBS | DMSO | CON. | |||||||
|---|---|---|---|---|---|---|---|---|---|---|
| Pathogen | A | B | C | D | A | B | C | D | ||
| Bacillus subtilis | 28 ± 1.2 a | 34 ± 1.0 b | 30 ± 0.9 a | 27 ± 0.9 a | 26 ± 0.6 a | 32 ± 1.6 b | 31 ± 1.5 ab | 25 ± 1.0 ac | 22 ± 0.6 | |
| Staphylococcus aureus | 23 ± 1.0 | 25 ± 2.0 | 28 ± 0.9 | 28 ± 1.0 | 21 ± 1.6 | 24 ± 0.9 | 23 ± 1.0 | 25 ± 1.9 | 15 ± 0.9 | |
| Escherichia coli | 21 ± 1.3 a | 40 ± 1.5 b | 32 ± 0.5 c | 25 ± 1.3 a | 19 ± 1.3 a | 38 ± 1.0 b | 27 ± 1.7 c | 23 ± 0.7 ac | 17 ± 1.0 | |
| Salmonella typhimurium | 22 ± 1.3 | N.A | 26 ± 1.3 | N.A | 20 ± 1.5 | N.A | 25 ± 2.2 | N.A | 23 ± 0.7 | |
Disclaimer/Publisher’s Note: The statements, opinions and data contained in all publications are solely those of the individual author(s) and contributor(s) and not of MDPI and/or the editor(s). MDPI and/or the editor(s) disclaim responsibility for any injury to people or property resulting from any ideas, methods, instructions or products referred to in the content. |
© 2023 by the authors. Licensee MDPI, Basel, Switzerland. This article is an open access article distributed under the terms and conditions of the Creative Commons Attribution (CC BY) license (https://creativecommons.org/licenses/by/4.0/).
Share and Cite
Elfar, S.A.; Bahgat, I.M.; Shebl, M.A.; Lihoreau, M.; Tawfik, M.M. Intraspecific Variability in Proteomic Profiles and Biological Activities of the Honey Bee Hemolymph. Insects 2023, 14, 365. https://doi.org/10.3390/insects14040365
Elfar SA, Bahgat IM, Shebl MA, Lihoreau M, Tawfik MM. Intraspecific Variability in Proteomic Profiles and Biological Activities of the Honey Bee Hemolymph. Insects. 2023; 14(4):365. https://doi.org/10.3390/insects14040365
Chicago/Turabian StyleElfar, Salma A., Iman M. Bahgat, Mohamed A. Shebl, Mathieu Lihoreau, and Mohamed M. Tawfik. 2023. "Intraspecific Variability in Proteomic Profiles and Biological Activities of the Honey Bee Hemolymph" Insects 14, no. 4: 365. https://doi.org/10.3390/insects14040365
APA StyleElfar, S. A., Bahgat, I. M., Shebl, M. A., Lihoreau, M., & Tawfik, M. M. (2023). Intraspecific Variability in Proteomic Profiles and Biological Activities of the Honey Bee Hemolymph. Insects, 14(4), 365. https://doi.org/10.3390/insects14040365








